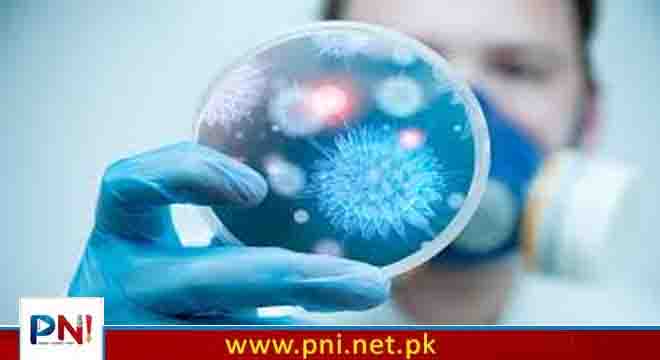

طبی ماہرین کا کہنا ہے کہ کہ کورونا، انفلوئنزا ایچ 1 این 1 اور سردیوں کے دیگر وائرل انفیکشن کی علامات ملتی جلتی ہیں۔
ڈاؤ اسپتال کے ماہر متعدی امراض پروفیسر سعید خان کا کہنا ہے کہ کراچی میں بڑی تعداد میں لوگ نزلہ، کھانسی اور بخار میں مبتلا ہو رہے ہیں۔ماہر متعدی امراض ڈاؤ اسپتال کے مطابق ٹیسٹ کروانے پر 25 سے 30 فیصد مریضوں میں کورونا مثبت آ رہا ہے، 10سے 12 فیصد مریضوں میں انفلوئنزا ایچ 1 این 1 کی تصدیق ہو رہی ہے۔ڈاو اسپتال کے پروفیسر سعید خان کا کہنا ہے کہ 5 سے 10 فیصد بچوں میں سانس کی نالی کے انفیکشن کی تصدیق ہو رہی ہے۔
دوسری جانب سول اسپتال کے ایم ایس ڈاکٹر نظام شیخ کا کہنا ہے کہ اکثر مریض ٹیسٹ نہیں کرواتے جس کے باعث بیماریوں کی تصدیق نہیں ہوتی، سول اسپتال میں وائرل انفیکشن کے یومیہ 200 مریض آرہے ہیں۔جناح اسپتال میں شعبہ ایمرجنسی کے انچارج ڈاکٹر عرفان نے بتایا کہ جے پی ایم سی میں وائرل انفیکشن کے یومیہ 150 سے 200 مریض آرہے ہیں۔
ترجمان محکمہ صحت سندھ کا کہنا ہے کہ سرکاری اسپتالوں میں فی الوقت کورونا کے ٹیسٹ کی سہولیات نہیں ہیں، کورونا وبا کے بعد لوگوں نے ٹیسٹ کروانا چھوڑ دیے تھے۔طبی ماہرین نے خیال ظاہر کیا ہے کہ وائرل انفیکشن اور دیگر بیماریوں سے بچنے کیلئے شہری احتیاطی تدابیر لازمی اپنائیں، شہری ماسک لازمی پہنیں اور خود کو ڈھانپ کر رکھیں۔طبی ماہرین کی جانب سے ہر سال انفلوئنزا کی ویکسین لازمی لگوانے کی بھی ہدایت کی جارہی ہے۔
تازہ ترین خبروں کے لیے پی این آئی کا فیس بک پیج فالو کریں